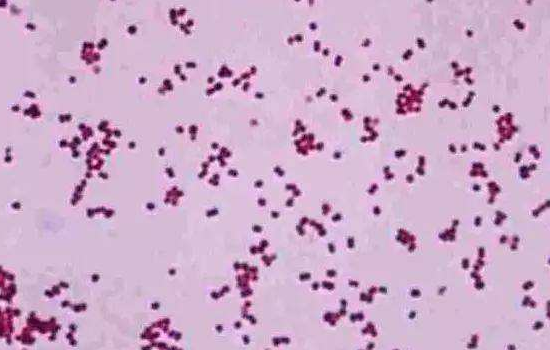
脑膜炎有哪些症状

脑膜炎严重了的确可以要了人的生命,脑膜炎一共有四种,不同的脑膜炎会有不同症状。
 化脓性脑膜炎是四种脑膜炎中最常见的脑膜炎,占所有脑膜炎病变的9成以上。它在发病时患者会出现呼吸道感染的早期症状,例如流涕、喉咙疼等症状,在进入败血期后又会出现高热、畏寒等症状。
化脓性脑膜炎是四种脑膜炎中最常见的脑膜炎,占所有脑膜炎病变的9成以上。它在发病时患者会出现呼吸道感染的早期症状,例如流涕、喉咙疼等症状,在进入败血期后又会出现高热、畏寒等症状。
其中不少病例的皮肤会出现暗或紫红色大小不等、分布不匀的瘀点或者瘀斑。该病发展到后期的时候,患者会感觉头疼,并且伴随着喷射状的呕吐症状。
 结核性的脑膜炎是儿童的多发病,也是引起儿童死亡的最主要的脑膜炎,但也不必害怕,在早期介入治疗后是完全可以治疗康复的,而且也完全没有什么后遗症。
结核性的脑膜炎是儿童的多发病,也是引起儿童死亡的最主要的脑膜炎,但也不必害怕,在早期介入治疗后是完全可以治疗康复的,而且也完全没有什么后遗症。
该病发病时患者的体温会升高,并且伴随着头痛、呕吐等症状,同时患者的会显示出脑膜刺激征,例如形成颅内高压早期脑脊液生成增多的症状。
顾名思义病毒性脑膜炎是由肠道病毒引起的一种脑膜炎,是急性发病,伴有剧烈的头痛、呕吐和发热,同时会引起全身的不适,不但会有精神萎靡、异常的情况,而且还有畏光、眩晕等症状的出现。这其中的一部分病患有可能出现咽峡炎、视力模糊等症状。
顾名思义病毒性脑膜炎是由肠道病毒引起的一种脑膜炎,是急性发病,伴有剧烈的头痛、呕吐和发热,同时会引起全身的不适,不但会有精神萎靡、异常的情况,而且还有畏光、眩晕等症状的出现。这其中的一部分病患有可能出现咽峡炎、视力模糊等症状。
 根据科学家的研究表明,隐球菌脑膜炎主要由鸽子的粪便引起,所以,有小孩的家庭建议不要饲养鸽子,隐球菌脑膜炎症状比较隐匿,或许会突然的发作。
根据科学家的研究表明,隐球菌脑膜炎主要由鸽子的粪便引起,所以,有小孩的家庭建议不要饲养鸽子,隐球菌脑膜炎症状比较隐匿,或许会突然的发作。
该病在发作时会出现会伴有低热、恶心呕吐、头痛等情况,同时也会出现相应的脑膜刺激征,选择真菌类药物治疗后病情会逐渐的缓解。



